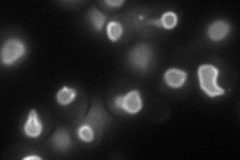
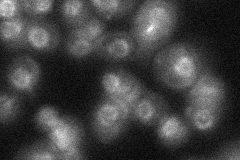

View description
Inner nuclear membrane (INM) protein; contains helix-extension-helix (HEH) motif, nuclear localization signal sequence; targeting to the INM requires the Srp1p-Kap95p karyopherins and the Ran cycle
Localization:
Intensity:
Fold change:
Significance:
-
C’ GFP library in SD

nuclear periphery21.69 -
N' NOP1pr-GFP in SD
nuclear periphery83.9625 -
N' TEF2pr-mCherry in SD

vacuole membrane77.5736 -
N' NATIVEpr-GFP in SD
nuclear periphery27.3726 -
N' TEF2pr-VC and Cyto-VN in SD

punctate,nuclear periphery36.9574 -
C’ GFP library in SD+DTT

nuclear periphery21.420.98No -
C’ GFP library in SD+H2O2

nuclear periphery23.11.06No -
C’ GFP library in Starvation Media

nuclear periphery17.510.8Yes -
C’ GFP library on the background of Pup2-DaMP

nuclear periphery -
C’ GFP library on the background of CCT mutant

nuclear periphery22.48861.03621No
